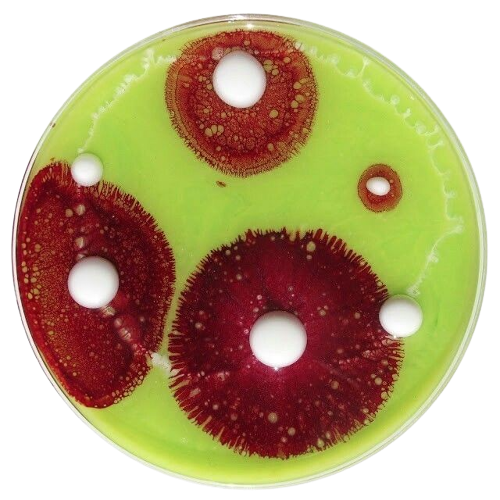

sam...
19 he/him lesbian
EN(T) sp784 fun haver
hiiii i'm sam ♡ i'm a 19 y/o majoring in laboratory science and i think i can digging for tubers. i have a job + college on my plate so activity can be real sporadic, but don't let that discourage you from interacting! i love love and i don't bite ♡♡♡i heart my girlfriend & my friends (!!!), duckman, seinfeld, sherlock holmes & related works, and a bunch of other stuff... we definitely have something in common! come play toys with me...♡my tumblr . art creds


sam...
19 he/him lesbian
EN(T) sp784 fun haver
hiiii i'm sam ♡ i'm a 19 y/o majoring in laboratory science and i think i can digging for tubers. i have a job + college on my plate so activity can be real sporadic, but don't let that discourage you from interacting! i love love and i don't bite ♡♡♡i heart my girlfriend & my friends (!!!), duckman, seinfeld, sherlock holmes & related works, and a bunch of other stuff... we definitely have something in common! come play toys with me...♡my tumblr . art creds

this is a page for my orphy <333 we haven't been together long but this has been the best time of my life <3 i luv u more than anything on this earth lambypoo
